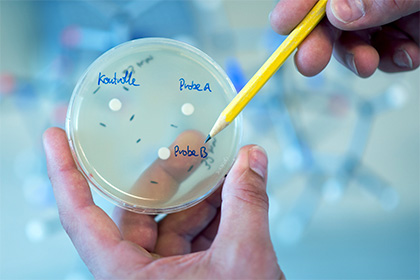

Ученые из Центра персонализированной иммунологии Австралийского национального университета выявили наследственную природу неописанного ранее заболевания. Некоторые из пациентов, у которых был отмечен данный синдром, более двадцати лет проходили одно обследование за другим и не получали точного диагноза. Теперь исследователи установили генетическую причину заболевания и определили механизм, объясняющий, как мутация вызывает болезнь.
ДНК человека
© EPA/MARCUS BRANDTПока еще не получивший названия синдром состоит в том, что из-за генетического дефекта иммунная система пациентов оказывается недостаточно активной в одних случаях, но проявляет чрезмерную агрессивность в других. В результате человек страдает от рецидивирующих инфекций, особенно заболеваний органов грудной полости, и одновременно у него отмечаются воспалительные процессы в лимфатических узлах, селезенке и на коже.
Исследователи в поисках причин редких заболеваний иммунной системы проводили полногеномное секвенирование ДНК своих пациентов, сопоставляя генетические варианты с работой их иммунных клеток. В ходе этой работы выяснилось, что некоторые из австралийских пациентов имеют тот же вариант одного из генов, который был независимо обнаружен японскими учеными, работавшими с семьей у представителей которой имелись сходные симптомы.
Чтобы окончательно убедиться в связи между мутацией и болезнью, австралийские исследователи ввели этот генетический вариант лабораторным мышам при помощи редактирования генома.
Руководитель исследования профессор Мэтью Кук (Matthew Cook) говорит, что полученный результат не только принесет определенность для пациентов, многие из которых долгие годы получали лечение от самых разных заболеваний, но и даст ценную информацию о работе организма, применимую для создания новых методов лечения и диагностики.
Источник: polit .ru